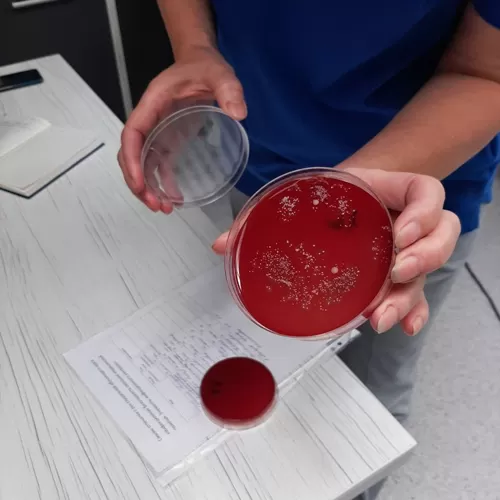

1. Повышение квалификации для рентген-эндоваскулярных хирургов «Эндоваскулярная хирургия сердечно-сосудистой системы», «Эндоваскулярная хирургия в аритмологии». Впервые обучение проводится на уникальном и единственном в стране виртуальном симуляторе для ангиографии «КатЛабВР», с использованием фантома сердца и магистральных сосудов для отработки навыков интервенционных вмешательств «CorView 3DR»
Обучение врачей эндоваскулярных хирургов по указанным программам позволит получить все необходимые мануальные навыки для работы как в областных центрах, так и в условиях региональных опорных больниц по острому коронарному синдрому (ОКС)в условиях региональных опорных клинических центров, повысить доступность эндоваскулярной хирургии для населения Республики Беларусь. Методы обучения: разбор основных теоретических аспектов эндоваскулярной хирургии сердечно-сосудистой системы, нарушений ритма и проводящей системы сердца и ее безопасности; практический разбор эндоваскулярной хирургии различных отделов сердечно-сосудистой системы при ИБС, различных нарушений ритма сердца с помощью высокотехнологичных тренажеров-симуляторов и life-операций из операционных Центра с двухсторонней аудио-видеосвязью с преподавателем, выступающим в роли оператора; разбор клинических случаев. Количество слушателей от 4 человек в группе. Стоимость на одного слушателя составляет 927,29. Продолжительность обучения – 5 дней (40 академических часа).
2. Повышение квалификации для врачей-эндоскопистов «Оперативная эндоскопия новообразований ЖКТ». В настоящее время активно развиваются и внедряются в клиническую практику оперативные эндоскопические методики удаления новообразований желудочно-кишечного тракта (ЖКТ), такие как эндоскопическая петлевая полипэктомия «холодной» петлей и диатермической петлей, эндоскопическая резекция слизистой (EMR), эндоскопическая диссекция в подслизистом слое (ESD). Выполнение каждого метода имеет свои стандартизованные требования в техническом и методологическом направлениях, в том числе и владение врачом-эндоскопистом определенными мануальными навыками. По этой причине, крайне актуальной для врачей является возможность обучения и отработки навыков оперативной эндоскопии без вреда для пациента. Данная проблема решается путем обучения на виртуальных эндоскопических симуляторах и биологических моделях. Такой метод обучения позволяет освоить стандартизированные эндоскопические методы удаления образований ЖКТ без риска для пациента, повторить их необходимое количество раз для освоения методики без риска получения реальных осложнений. При данном методе обучения под контролем преподавателя в реальном времени производится разбор и исправление возникающих ошибок, объективно оценивается достигнутый уровень выполнения манипуляций. Использование в обучении биологических моделей позволяет создать условия максимально приближенные к реальным. Количество слушателей от 4 человек в группе. Стоимость на одного слушателя составляет 783.88. Продолжительность обучения – 5 дней (40 академических часа).
3. Обучающий курс «Инфекционная безопасность оказания медицинской помощи, элементы инфекционного контроля для врачей-специалистов и медицинских сестер».
Цель обучающего курса – профессиональное усовершенствование врачей-специалистов (инфекционистов, реаниматологов, терапевтов, пульмонологов, хирургов, эпидемиологов и др.), а также среднего медицинского персонала по наиболее актуальным теоретическим и практико-методическим вопросам инфекционного контроля в учреждении здравоохранения.
Задачи обучающего курса: приобретение, расширение и систематизация знаний о системе инфекционного контроля, о современных методах и средствах дезинфекции и стерилизации. Подходы к разработке схем антибактериальной периоперационной профилактики при проведении оперативных вмешательств. Разработка оптимальных схем антибактериальной терапии пациентов с послеоперационными осложнениями.
Продолжительность обучения – 3 дней (24 академических часа). Количество слушателей от 4 человек в группе. Стоимость на одного слушателя составляет 261.55.
Занятия проводят высококвалифицированные специалисты РКМЦ. По окончании курса выдается документы об обучении и образовании установленного образца и сертификат.
Приглашаем всех заинтересованных на обучение!
Знайте по-новому! Учитесь по-новому!